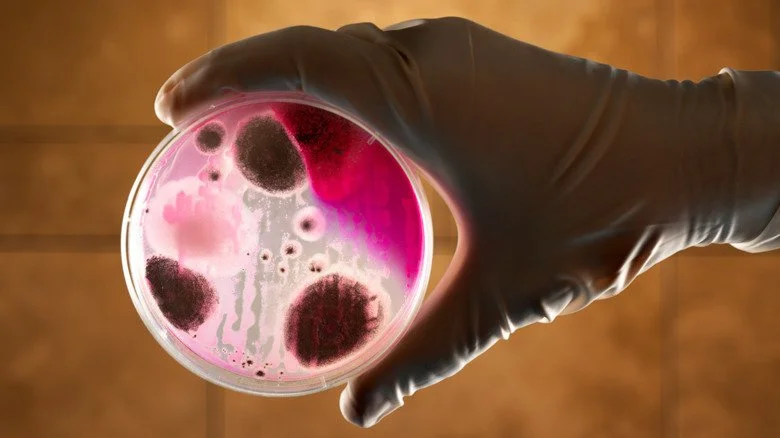
anthrax in a petri dish

Sommaire
Les Poisons : Comprendre leur Toxicité

Commençons par les bases : qu’est-ce qui est exactement considéré comme un poison ? Selon les Centres de Contrôle et de Prévention des Maladies, il s’agit de « toute substance, y compris les médicaments, qui est nuisible à votre corps si elle est ingérée, inhalée, injectée ou absorbée en trop grande quantité. » Les produits chimiques, médicaments et gaz sont tous classés comme poisons, selon le Mayo Clinic. Mais alors, comment détermine-t-on quels sont les poisons les plus mortels ?
Les poisons agissent de différentes manières pour provoquer des décès. Les chercheurs mesurent donc la toxicité à l’aide de plusieurs méthodes. D’après le Centre canadien d’hygiène et de sécurité au travail, deux des plus pertinentes sont le LD50 et le LC50. Ces abréviations signifient Dose Létale et Concentration Létale, respectivement, et ils font référence à la quantité d’une substance nécessaire pour causer la mort chez 50 % des animaux testés, généralement des souris et des rats.
Les résultats de ces études sont ensuite intégrés dans des tableaux classant les substances de leur toxicité extrême à celles qui ne le sont pas du tout. Ce sont les poisons les plus extrêmes qui suscitent une fascination morbide. Examinons donc certains des poisons les plus mortels découverts ou créés par l’humanité… sans ordre particulier.
Le gaz utilisé lors de l’attaque chimique la plus terrifiante des années 1990

La plupart des gens pensent qu’en vaquant à leurs occupations quotidiennes, ils sont à l’abri de choses aussi catastrophiques que des attaques chimiques. Cependant, cela a changé en 1995, lorsque des citoyens ordinaires, dans leur routine habituelle, ont inhélé — et sont morts — à cause d’une attaque au gaz sur cinq trains à Tokyo. Les responsables de ces attaques étaient des membres de la secte Aum Shinrikyo, qui ont causé la mort de 13 personnes, selon la BBC. Des milliers d’autres ont été blessés, et cet incident représentait une escalade par rapport à une attaque qu’ils avaient réalisée l’année précédente.
Le gaz utilisé était le sarin : les colis laissés par Aum Shinrikyo contenaient un mélange dont 30 % était composé de cet agent neurotoxique mortel. Selon les CDC, une exposition de seulement un millilitre de sarin sur la peau peut être fatale, et la manière de mourir est particulièrement horrible. La seule bonne nouvelle est qu’avec une forte dose, la mort peut survenir entre 1 et 10 minutes, mais le revers de la médaille est qu’une exposition légère peut ne pas montrer de symptômes pendant jusqu’à 18 heures. Les symptômes incluent des convulsions, une paralysie, un effondrement respiratoire, une défaillance des systèmes vitaux du corps et même la noyade dans des liquides corporels en excès.
Il est fort probable que les survivants souffrent de dommages cérébraux permanents, et le plus tragique est que cet agent créé par les nazis continue d’être utilisé dans des attaques terroristes à travers le monde, selon le National Interest.
Un poison emblématique de la fiction criminelle

L’arsenic est sans conteste l’un des poisons les plus évoqués dans la fiction criminelle, et cela pour de bonnes raisons. Selon des études, il suffit de 0,145 gramme — soit environ un huitième de cuillère à café — pour tuer un adulte. Ce poison est prisé en raison de ses effets retardés : la mort peut survenir après des doses faibles administrées de façon répétée, ce qui entraîne une exposition chronique. Les symptômes de l’intoxication comprennent une baisse de la production de globules rouges et blancs, provoquant une réaction en chaîne dans le corps. D’autres problèmes tels que des troubles gastro-intestinaux apparaissent également, et en cas d’exposition à long terme, le risque de certains cancers, de troubles du système nerveux et de dysfonctionnements du système circulatoire augmente considérablement.
Historique, l’arsenic a longtemps été utilisé comme arme meurtrière. L’un des cas les plus emblématiques est celui de Madeleine Smith, jugée en 1857 pour la mort de son amant, Pierre Emile L’Angelier. Cette affaire est souvent qualifiée de « crime du siècle », notamment lorsque les contenus de leurs lettres d’amour ont été rendus publics. Finalement, le verdict rendu fut « non prouvé ».
Bien que l’arsenic soit encore utilisé de nos jours pour commettre des meurtres, la science moderne réussit mieux à le détecter. En 2007, une affaire médiatisée rapportée par CNN a vu Cynthia Sommer reconnue coupable d’avoir tué son mari en lui administrant une dose mortelle d’arsenic.
Il n’existe aucune dose sans danger

Le plomb est l’un de ces éléments dont on parle fréquemment, à tel point qu’il est facile d’oublier à quel point il peut être mortel. Selon Christopher P. Holstege, professeur de médecine d’urgence et de pédiatrie à l’Université de Virginie, le corps humain n’utilise le plomb d’aucune manière utile et ne parvient pas à l’éliminer naturellement. Holstege affirme que le plomb est considéré comme toxique, quelle que soit sa quantité ou son origine.
L’Organisation mondiale de la santé (OMS) partage cet avis, en soulignant que l’intoxication au plomb peut avoir des conséquences dévastatrices sur la santé des personnes de tous âges, mais elle est particulièrement évidente chez les jeunes enfants. En effet, ces derniers sont exposés à des niveaux plus élevés de plomb, même de très faibles doses pouvant entraîner des conséquences catastrophiques.
La moindre quantité de plomb dans le sang peut entraîner des problèmes permanents chez ceux qui survivent, comme des changements de comportement, le développement de comportements antisociaux et des dommages aux organes. Holstege met en garde sur le fait que le plomb est si dangereux parce qu’il interfère avec les processus biologiques à un niveau cellulaire avant d’être déposé et stocké dans les os, ce qui provoque un véritable chaos et des résultats dévastateurs.
Selon l’OMS, plus de 1,06 million de personnes sont décédées de causes liées au plomb en 2017, et la population mondiale a perdu 24,4 millions d’années de vie en bonne santé à cause de cette toxicité.
Ce poison naturel est un sous-produit d’un aliment courant

Le ricin est une substance qui ressemble un peu à du sel de table. Imaginez quelques grains et c’est la quantité nécessaire pour tuer un adulte. Ce poison provient de la graine de ricin, qui est également la source de l’huile de ricin, un ingrédient courant dans nos cuisines. Lors de l’extraction de cette huile, le ricin reste comme un sous-produit, et dire que l’exposition à ce poison est extrêmement désagréable est un euphémisme.
Les effets du ricin dépendent de la manière dont il a été administré. S’il est ingéré, il provoque de graves troubles gastro-intestinaux entraînant déshydratation et défaillance organique. En cas d’inhalation, il peut induire une défaillance respiratoire due à l’accumulation de fluide dans les poumons. Une injection est aussi possible, et les effets varient selon le site d’injection, mais impliquent généralement une défaillance progressive des organes.
La possibilité d’utiliser le ricin comme arme n’est pas nouvelle. Les États-Unis ont envisagé son utilisation durant la Première Guerre mondiale, tandis que les Britanniques ont mené un programme top secret pour développer une bombe avec ce qu’ils appelaient le Composé W. Plus récemment, en 2018, 2013 et 2003, des enveloppes contenant du ricin ont été envoyées à des personnalités à Washington, D.C., y compris à l’ancien Président Barack Obama. Toujours en 2018, il a été rapporté qu’une perquisition dans un appartement à Cologne, en Allemagne, avait permis de saisir 3 000 graines de ricin et 84,5 milligrammes de ricin.
Le poison pour rats au cœur de morts mystérieuses

À la fin du XIXe siècle, Thomas Neill Cream a tué un nombre indéterminé de femmes avant d’être enfin jugé, condamné et pendu en Angleterre. Cette histoire incroyable s’étend sur trois pays et quelques décennies, impliquant un médecin profondément misogyne (même pour son époque) qui a laissé un sillage de corps derrière lui. Alors qu’il se trouvait dans l’Illinois, il a envoyé une série de télégrammes au coroner en charge de la mort de Daniel Stott, insistant sur le fait que celui-ci était mort d’une dose mortelle de strychnine — ce qui était vrai, puisque Cream lui avait administré ce poison. La première autopsie a mené à son arrestation, mais il a continué à tuer après son pardon et sa libération, utilisant toujours la strychnine.
La strychnine, selon le CDC, peut être ingérée, inhalée ou même absorbée par les muqueuses. Même une petite quantité est suffisante pour provoquer la mort, en perturbant la communication entre les nerfs et les muscles. L’agitation et les spasmes musculaires cèdent alors la place à l’épuisement, l’insuffisance respiratoire, la défaillance cérébrale et, finalement, la mort.
En plus d’être une arme favorite des écrivains tels qu’Agatha Christie et Sir Arthur Conan Doyle, la strychnine est principalement utilisée comme poison pour rats… et, comme l’affirme Forbes, comme substance améliorant la performance. Elle a été au cœur du premier scandale de dopage aux Jeux Olympiques en 1904, bien que les effets initiaux du poison aient suffi à propulser l’athlète à la première place, il s’est effondré après la course.
Créé avec les meilleures intentions

En théorie, le thalidomide devait être un médicament bénéfique. Selon le Musée de la Science, ce médicament, initialement conçu comme sédatif, s’est révélé efficace pour traiter les femmes souffrant de nausées matinales sévères. Cependant, il a engendré des conséquences choquantes. Même s’il n’a jamais été approuvé aux États-Unis, il a été autorisé en vente libre dans des pays européens tels que l’Allemagne et le Royaume-Uni, entrant sur le marché à la fin des années 1950, se répandant finalement dans 49 pays différents.
Il a fallu cinq ans aux médecins pour établir le lien entre ce médicament et les malformations congénitales dévastatrices ainsi que des décès. Bien qu’on ignore combien de bébés ont perdu la vie après que leurs mères aient pris du thalidomide, parmi plus de 10 000 bébés touchés par le médicament, environ la moitié seraient décédés. Selon The Guardian, cela incluait environ 6 000 fausses couches, 2 000 naissances mortes et 2 000 autres bébés décédés en tant que nourrissons. Celles-ci ne concernent que le Royaume-Uni : au niveau mondial, on estime que le thalidomide serait responsable d’environ 80 000 décès chez les nourrissons.
Comment cela a-t-il pu se produire ? Le thalidomide a été approuvé uniquement sur la base des résultats des tests LD50 effectués uniquement sur des animaux. Ces résultats étaient extrêmement prometteurs, et lorsque les chercheurs de la société allemande Chemie Grunenthal GmbH ont constaté qu’il était presque impossible de donner une quantité de thalidomide suffisante pour nuire à leurs sujets de test animaux, ils ont supposé qu’il en serait de même pour les humains. Ce n’était pas le cas.
Des montres qui brillent dans le noir, mais pas si inoffensives

Les belles montres qui brillent dans le noir évoquent des souvenirs nostalgiques d’une époque où la découverte du radium par Marie et Pierre Curie en 1898 fut accueillie comme une innovation fascinante. Ce minéral, capable d’émettre une lumière éclatante, suscita un engouement immédiat. Rapidement, des entreprises s’illuminèrent d’idées en mélangeant cette substance avec du sulfure de zinc pour créer une peinture qui captivait le public.
Appelée par divers noms, tels qu’Undark et Luna, cette peinture devint très populaire. Beaucoup de personnes prenaient plaisir à s’en badigeonner, charmées par l’idée de briller dans l’obscurité. Des dizaines de travailleurs étaient engagés pour appliquer cette peinture sur les cadrans des montres et les instruments d’aviation. Parallèlement, des médecins prescrivaient le radium pour presque toutes les affections, l’intégrant même dans des produits cosmétiques et des dentifrices. Le radium était omniprésent, mais cet engouement aveuglant conduisit à de terribles conséquences.
Les utilisateurs réguliers de ce produit, en particulier les célèbres « Radium Girls », paidèrent un lourd tribut pour cette tendance. Ces femmes, qui trempaient leurs pinceaux dans la peinture puis les portaient à leurs lèvres pour les affiner, souffrirent de dégradations corporelles alarmantes. Leur santé se détériorait inexorablement : leurs os se désintégraient, leurs dents tombaient et leur peau se déchirait au moindre contact. Face à la montée des décès parmi leurs camarades, les survivantes décidèrent de poursuivre en justice la société U.S. Radium pour obtenir réparation. Selon certaines sources, des corps furent exhumés pour prouver qu’ils n’étaient pas décédés de la syphilis comme le prétendait l’entreprise, mais bien d’une intoxication au radium.
Le poison au cœur de l’une des théories du complot les plus étranges de l’histoire

Certaines personnes s’engagent pleinement dans même les théories du complot les plus étranges, comme celle qui prétend qu’Adolf Hitler n’est pas mort, mais aurait plutôt fui l’Allemagne pour se réfugier en Amérique du Sud. En 2018, le European Journal of Internal Medicine a publié une étude qui confirmait que le crâne et les dents supposés d’Hitler étaient bien les siens. L’équipe française a également découvert des dépôts de couleur bleue, formés selon eux par une réaction entre le métal de ses prothèses dentaires et le poison qu’il avait utilisé pour mettre fin à ses jours : le cyanure.
Le cyanure est une substance naturellement présente dans une grande variété de fruits, et selon les données du CDC, il se décline sous plusieurs formes. Sa toxicité dépend de la dose : une exposition légère peut provoquer des maux de tête et des étourdissements, tandis que des quantités plus importantes mènent à des défaillances respiratoires, des convulsions, un rythme cardiaque ralenti, et même la mort.
Réaction d’une personne à cette substance varie, et les États-Unis ont eu un aperçu terrifiant de l’effet du cyanure en 1982. C’est à cette date que des décès sont survenus suite à la consommation de Tylenol contaminé, la première victime étant une fillette de 12 ans, Mary Kellerman. Face à cette série de morts, Johnson & Johnson a rappelé 31 millions de flacons, modifié l’emballage de sécurité des médicaments et offert une récompense pour des informations sur le coupable. Malheureusement, celui-ci n’a jamais été retrouvé.
Plus mortel que la guerre du Vietnam

Le Vietnam Veterans Memorial Fund indique que les noms ajoutés au mémorial du Vietnam en 2021 portent le total à 58 281. Ce qui est particulièrement choquant, c’est que 2,8 millions de personnes ont par la suite souffert de maladies graves ou d’effets à long terme après avoir été exposées à l’agent orange. L’agent orange, utilisé pour détruire la jungle et rendre vulnérables les stratégies du Viet Cong, s’est avéré aussi mortel pour les humains qu’il l’était pour la végétation.
Ce herbicide a été déversé dans des quantités colossales sur les troupes américaines : sur environ 20 millions de gallons d’herbicides utilisés, 13 millions étaient de l’agent orange. Sa létalité provient d’un composé appelé 2,3,7,8-tétrachlorodibenzodioxine, ou TCDD. Faisant partie d’un groupe de substances chimiques nommées dioxines, il est lié à des taux élevés de maladies cardiaques, de troubles hormonaux, de cancers, de problèmes du système immunitaire et nerveux, ainsi qu’à des décès prématurés.
Environ 4 millions de Vietnamiens ont également été exposés, et en 2021, un article du New York Times a mis en lumière les effets persistants ressenti par la plus jeune génération. Des villageois de Labeng-Khok ont été interviewés, parmi lesquels des familles avec des enfants présentant des malformations congénitales graves, comme cette petite fille qui est décédée à l’âge de 2 ans. Son arrière-oncle a dépeint son état en ces termes : « Elle ne pouvait pas se redresser. Son corps était mou, comme s’il n’y avait pas d’os. »
Des créatures fascinantes et mortelles

Les poissons-globes, avec leur apparence amusante et leur capacité à flotter comme de grosses balles, semblent tout droit sortis d’un film Disney sous-marin. Cependant, leur comportement lent et leur vulnérabilité apparente face aux prédateurs sont précisément les raisons pour lesquelles les biologistes estiment qu’ils ont développé des mécanismes de défense, tels que des épines et la possibilité de s’inflater. Mais le plus dissuasif reste la présence d’un poison mortel : la tétrodotoxine.
Selon des informations, un seul poisson-globe contient suffisamment de TTX pour tuer trente personnes, ce qui soulève des questions quant à la fascination pour cette délicatesse culinaire. Bien que des chefs expérimentés puissent, en théorie, préparer ce poisson de manière sécuritaire, les empoisonnements sont fréquents et peuvent avoir des conséquences catastrophiques.
La tétrodotoxine provoque une série de symptômes préalables à la mort, en perturbant la transmission des signaux nerveux aux muscles. Les manifestations varient de l’engourdissement et des vertiges jusqu’aux difficultés d’élocution et de contrôle des mouvements. Cela peut rapidement évoluer vers une paralysie du système respiratoire, un rythme cardiaque anormal, des convulsions, et la mort peut survenir dans les vingt minutes suivant l’ingestion du poison.
Les dangers des champignons mortels

Les champignons sont souvent un sujet de passion ou de dégoût, et même ceux qui les apprécient devraient éviter à tout prix d’approcher le fameux « champignon de la mort ». Considéré par certains comme l’un des plus savoureux, ce champignon mortel mérite pourtant toute notre méfiance. En effet, rien n’est si délicieux qu’il vaille le risque d’une telle issue fatale.
Contrairement à d’autres toxines présentes dans certains champignons, les amatoxines, substances actives contenues dans le champignon de la mort, ne peuvent pas être éliminées. Une fois ingérées, elles provoquent des symptômes entre 6 et 24 heures après l’ingestion, que l’on pourrait confondre avec une grave grippe. Par la suite, les amatoxines pénètrent dans le foie, où elles perturbent la capacité de cet organe à produire des protéines, déclenchant alors une réaction en chaîne qui mène à l’échec des autres organes.
Si les toxines ne parviennent pas à faire leur effet du premier coup, elles entrent dans un cycle destructeur : voyageant du foie à la vésicule biliaire, à l’intestin grêle et revenant au foie, infligeant encore plus de dommages. Pendant ce temps, les amatoxines qui n’ont pas été captées par le foie attaquent les reins, entraînant également leur défaillance.
Bien que des traitements de soutien puissent atténuer les effets, le diagnostic précoce d’une intoxication est délicat. À noter que les champignons de la mort ont su s’adapter pour croître non seulement sous les chênes européens, mais également sous ceux de Californie. Cette adaptation a permis leur propagation fulgurante à travers l’Amérique du Nord, comme l’indique une analyse récente.
Génèse du Zyklon B

Chaque individu qui descendait des trains aux camps de concentration nazis tels qu’Auschwitz faisait l’objet d’un processus de sélection en une fraction de seconde. Ceux jugés aptes étaient dirigés vers les « douches », où on leur disait de se déshabiller et de pénétrer à l’intérieur. Selon ThoughtCo, environ un million de personnes ont trouvé la mort après avoir été gazées avec du Zyklon B. Mais qu’est-ce que c’était réellement ?
Dans une tournure étrange, la BBC révèle que l’inventeur du Zyklon B était un chimiste juif. Fritz Haber a commencé sa carrière en cherchant à améliorer les engrais chimiques, mais pendant la Première Guerre mondiale, il s’est tourné vers des armes destinées à abréger les conflits. Son gaz chloré a été utilisé pour la première fois en 1915, mais à la fin de la guerre, il était relativement sûr qu’il serait jugé pour crimes de guerre. Pour tenter de devancer ce destin, il s’est entièrement engagé auprès de l’Allemagne, jusqu’à ce que l’antisémitisme le force à fuir en exil.
C’est la recherche de Haber qui a été transformée en Zyklon B, et ses proches étaient parmi les victimes. La substance chimique est en réalité du cyanure d’hydrogène, fabriqué sous forme de pelotes bleuâtres qui réagissent au contact de l’air. Elle a été testée pour la première fois sur 850 prisonniers polonais et soviétiques le 3 septembre 1941, et le processus ne prenait que quelques minutes. Lors du procès d’Oskar Groening, comptable à Auschwitz, des experts ont témoigné (via The Statesman) que cette substance tuait en provoquant des convulsions, des douleurs agonisantes et un arrêt cardiaque. Les concentrations élevées entraînaient une mort plus rapide, laissant certains à souffrir pendant jusqu’à une demi-heure.
Le poison le plus susceptible d’être utilisé dans une attaque bioterroriste
Lorsqu’il s’agit des différentes méthodes pour causer un grand nombre de morts, les options ne manquent pas. Selon les experts, l’anthrax est l’un des poisons les plus susceptibles d’être à nouveau utilisé lors d’une attaque terroriste, et ceci pour plusieurs raisons. En effet, lorsqu’il est inhalé et qu’aucun traitement n’est administré, il est fatal quasiment à 100% des cas.
Une des raisons qui explique pourquoi il est difficile de se faire soigner à temps est la lenteur d’apparition des symptômes. Ceux-ci peuvent mettre entre une semaine et deux mois à se manifester, et au début, l’anthrax peut ressembler à un simple rhume ou à la grippe. Ces symptômes initiaux peuvent durer quelques jours, et en l’absence de diagnostic adéquat, la maladie peut dégénérer en pneumonie, provoquer un effondrement du système respiratoire et entraîner la mort.
L’anthrax a fait les gros titres en 2001, lorsque des lettres contenant des spores ont été envoyées aux médias américains, causant la mort de cinq personnes. Il est toujours considéré comme un agent biologique de catégorie 1, représentant une menace sérieuse. Étrangement, un vaccin a été développé dès 1881, un chiffre qui semble presque incroyable. Cela dit, l’anthrax est un agent biologique, se favorisant dans les produits animaux comme le bois et le cuir, mettant ainsi depuis longtemps en danger ceux travaillant dans l’industrie textile. Il y a longtemps, l’intoxication par l’anthrax était désignée sous le nom de « maladie des triages de laine ».
Le dangereux agent neurotoxique qui a tué en Corée du Nord

En 2017, les médias rapportaient que Kim Jong-nam, fils de Kim Jong-il de Corée du Nord, avait été tué avec un agent neurotoxique mortel appelé VX. Cela s’est produit malgré le fait que, théoriquement, la plupart des stocks mondiaux de VX avaient été éliminés en 1997. Selon le New York Times, cet agent était interdit par la Convention sur les armes chimiques.
Il suffit de 10 milligrammes de VX pour provoquer la mort, agissant par contact cutané ou inhalation. Cet agent perturbe la fonction musculaire, rendant impossible la relaxation des muscles du corps, entraînant ainsi un arrêt respiratoire. Bien qu’il existe un antidote pour combattre les effets mortels du VX, le décès peut survenir en quelques minutes après une exposition, rendant souvent l’antidote inefficace.
Le culte japonais Aum Shinrikyo a expérimenté le VX en 1995, tuant trois personnes quelques mois avant de libérer du gaz sarin dans un train à Tokyo. Comme rapporté par The Guardian, l’une de leurs victimes ciblées, Hiroyuki Nagaoka, a échappé à une dose létale lorsqu’il a été aspergé sur le col de sa veste. Cependant, des années plus tard, il souffre encore d’engourdissement et a besoin d’un tube respiratoire.
Un poison répandu dans nos foyers

Le mercure est un élément qui a trouvé de nombreuses applications au fil des siècles, et la plupart d’entre nous le connaissent surtout comme le liquide qui permet de faire fonctionner les thermomètres. Bien qu’il soit extraordinairement toxique, son effet est quelque peu surprenant. Selon le toxicologue Thomas Gebel de l’Institut Fédéral de la Santé et de la Sécurité au Travail en Allemagne, « boire du mercure a un effet laxatif. Sa densité nettoie merveilleusement les intestins. Pris par voie orale, sans inhalation, il y a presque aucun risque. »
Cependant, il a insisté sur le fait qu’il ne faut en aucun cas boire du mercure. En effet, celui-ci devient mortel lorsqu’il s’évapore et est inhalé. Les personnes qui, au cours du XIXe siècle, en avaient ingéré allaient inévitablement inhaler aussi des vapeurs. Malheureusement, la plupart de ceux qui ont été traités par le mercure ont succombé à sa toxicité, car le mercure vaporisé se dirige directement vers le cerveau, les poumons et le sang, provoquant des problèmes aussi variés que des conditions neurologiques appelées érethisme mercuriel, des troubles du sommeil, de la paralysie, et dans le pire des cas, la mort.
Cela demeure un problème majeur aujourd’hui. En 2021, un article de Reuters a mis en lumière la situation de la tribu Munduruku au Brésil, qui est confrontée à la menace mortelle du mercure. La levée des restrictions environnementales a permis aux chercheurs d’or d’envahir leurs terres et de continuer à utiliser le mercure pour traiter les sédiments aurifères. Les conséquences sont dévastatrices, car l’eau contaminée par le mercure a entraîné des maladies chroniques, des tumeurs cancéreuses, des problèmes de mémoire, des troubles de l’humeur, et des décès prématurés.
Ce qui rend ces petites grenouilles si mortelles

La grenouille à fléchettes est l’un des animaux les plus dangereux des Amériques. Bien qu’elles soient indéniablement mignonnes, leurs couleurs vives servent d’avertissement aux prédateurs potentiels. Ces grenouilles sont capables de synthétiser une multitude de poisons, et une seule d’entre elles peut contenir suffisamment de toxine pour tuer dix hommes adultes. Cela fait près de 40 millions d’années qu’elles se protègent de cette manière, et parlons d’un des plus de 800 alcaloïdes que les chercheurs ont isolés de ces grenouilles.
La grenouille dorée est dotée d’une neurotoxine appelée batrachotoxine. Son principal mécanisme de défense consiste à sécréter ce poison lorsqu’elle se sent menacée. Une quantité équivalente à deux grains de sel suffit pour tuer un adulte en environ dix minutes, et la mort n’est pas agréable. Selon la Royal Society of Chemistry, ce poison perturbe la communication entre les muscles et les nerfs, entraînant finalement la paralysie, l’insuffisance cardiaque, et la mort. Science Alert souligne qu’il n’existe qu’un seul animal – une espèce de serpent – qui ne succombe pas immédiatement à son contact. Et il n’y a pas d’antidote.
Un fait fascinant à noter : lorsqu’elles sont élevées en captivité, ces grenouilles deviennent parfaitement inoffensives. Celles qui sont capturées dans la nature et mises en captivité perdent lentement leur toxicité… et personne ne sait vraiment pourquoi.
Les poisons mortels du monde

Parmi les substances souvent méconnues sous leur véritable nom, on retrouve le Botox. Ce composant, utilisé couramment pour atténuer les rides, agit en paralysant les nerfs, empêchant ainsi la contraction des muscles responsables de ces lignes. Cela peut sembler dangereux, et c’est en effet le cas.
Rietie Venter, responsable de la microbiologie à l’Université d’Australie-Méridionale, explique que l’efficacité du Botox provient d’une bactérie appelée toxine botulinique, la neurotoxine la plus puissante connue de l’homme. Ce même poison est à l’origine du botulisme, une forme d’intoxication alimentaire dont la gravité est telle qu’environ 65 % des personnes qui en souffrent décèdent sans traitement immédiat. Même avec des soins appropriés, de nombreuses victimes subissent des effets durables, tels que des vertiges et de la fatigue.
La toxine botulinique, qui est environ 7 millions de fois plus puissante que le venin d’un cobra, provient du sol et de la bactérie C. botulinum. Les spores peuvent résister à des conditions extrêmes, comme la cuisson, et ceux qui ingèrent cette toxine ressentent initialement des difficultés à se concentrer. Cela évolue ensuite vers des problèmes de déglutition, avec une paralysie progressive de plus en plus de muscles. La mort survient lorsque le système respiratoire s’arrête — une fin particulièrement redoutable.
